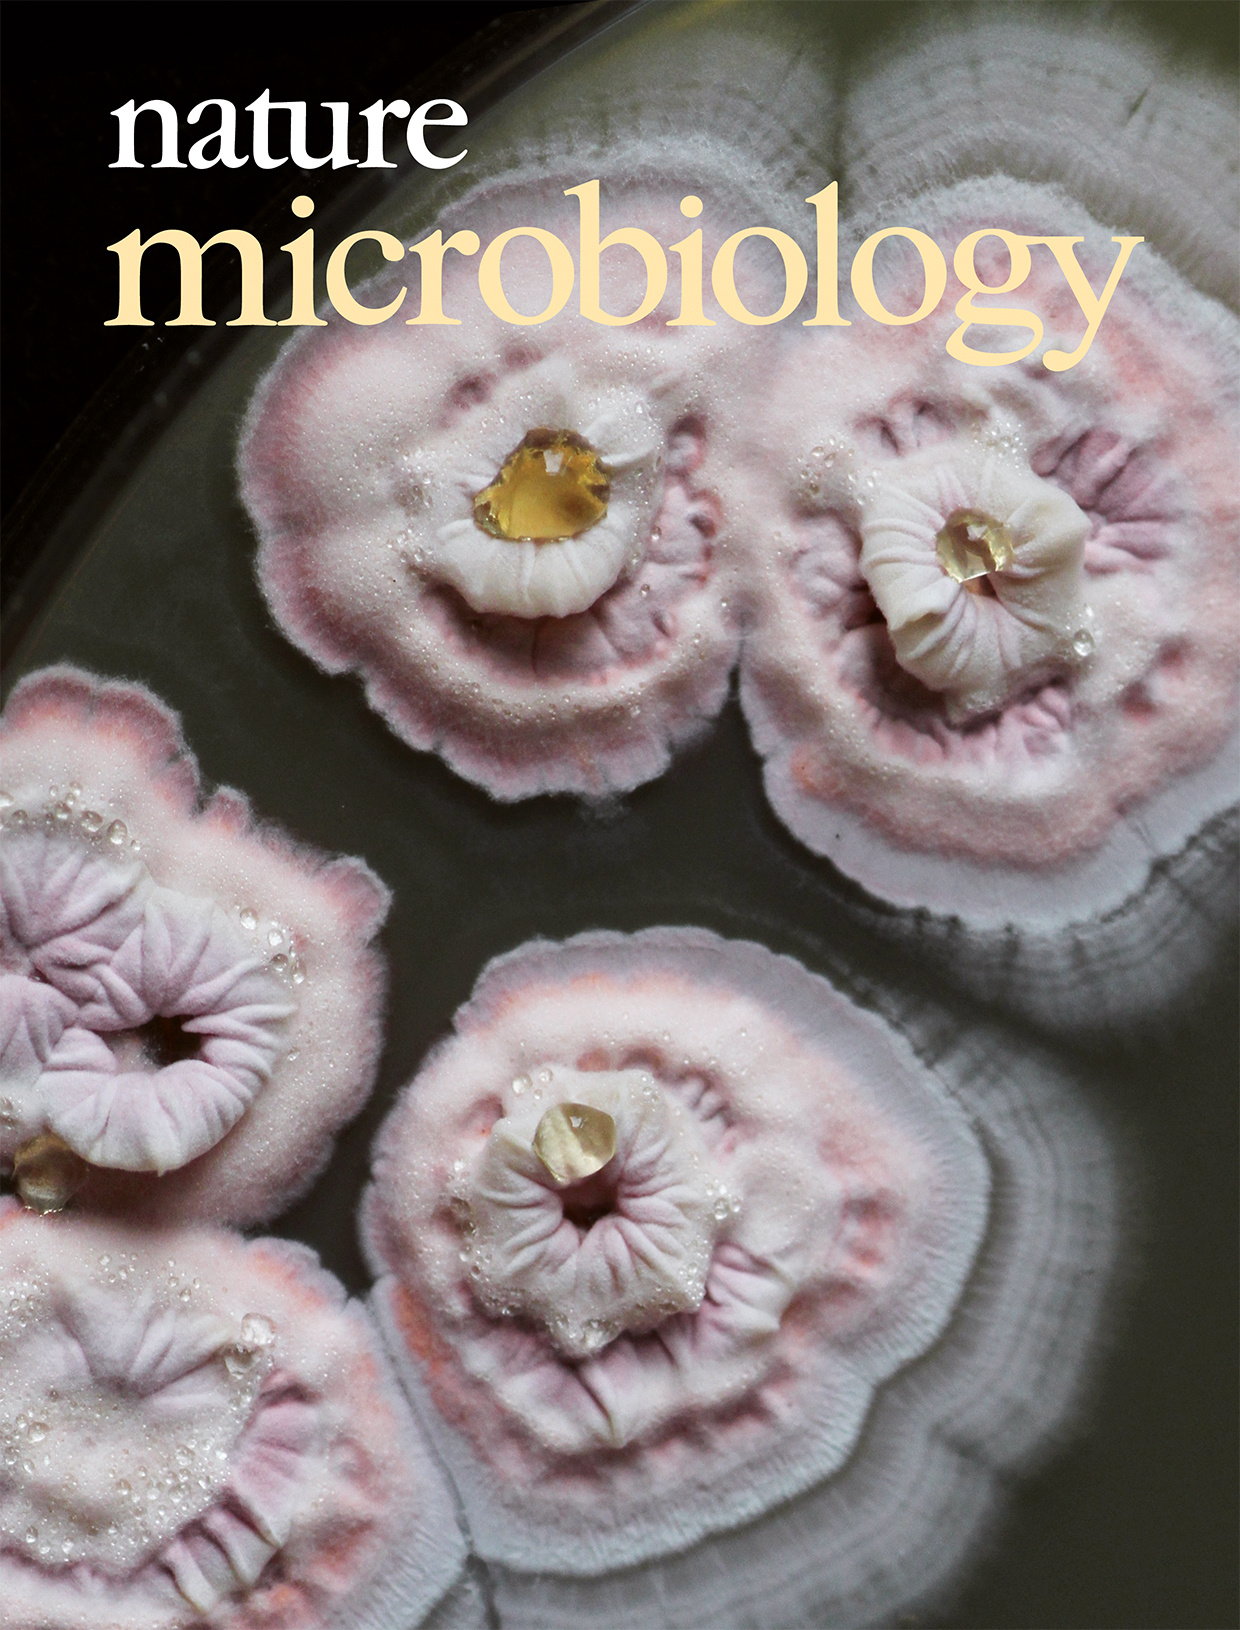

March 2017 cover
Establishing the RodA peptidoglycan polymerase as an antibiotic target. Image by Kaveh Emami; cover design by Samantha Whitham.
Published in Microbiology
Hot rod
RodA is a glycosyltransferase found in Bacillus subtilis; bacterial extracts may be able to target the peptidoglycan polymerase pathway and serve as an antibiotic.
Refers to "RodA as the missing glycosyltransferase in Bacillus subtilis and antibiotic discovery for the peptidoglycan polymerase pathway" by Emami et al.
Nature Microbiology 2: 16253 (2017)
Follow the Topic
Microbiology
Life Sciences > Biological Sciences > Microbiology
Please sign in or register for FREE
If you are a registered user on Research Communities by Springer Nature, please sign in